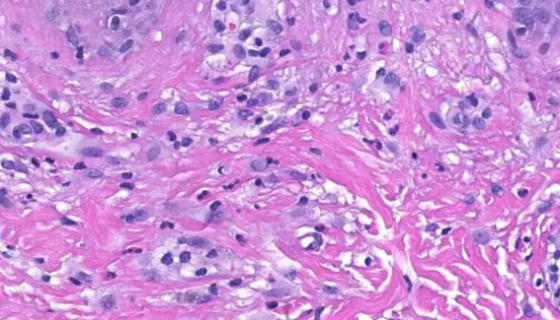
人角质形成细胞的使用与组成及主要作用！

黄曲霉素的知识介绍与理化性质及产生条件!
黄曲霉素(黄曲霉素)一般指黄曲霉毒素。黄曲霉毒素(AFT)是...

人真皮乳突细胞HDPCs的处理方法与注意事项!
真皮毛乳头细胞位于毛囊基底部,是一类成纤维细胞。在毛囊发育早...

ACCC 10543 红平红球菌的形态特征与菌株优势!
红平红球菌是Rhodococcus属的微生物,原产地为中国。...

鸡巨噬细胞的生长条件与培养操作流程及注意事项!
鸡巨噬细胞的生长条件与培养操作流程及注意事项有哪些?

人肾癌细胞的处理方法与培养步骤及注意事项!
人肾癌细胞收到后的处理方法与培养步骤及注意事项有哪些?
人角质形成细胞的使用与组成及主要作用!
角质形成细胞是一种不断分化的复层鳞状上皮细胞,其分化的最终阶...

鲤鱼上皮细胞的运输和保存及注意事项有哪些?
鲤鱼上皮细胞分离自脑组织;大脑分左右两个半球,大脑皮质(灰质...

H9c2(2-1)(大鼠心肌细胞)的收发货处理方法!
H9c2(2-1)细胞是一株由Kimes·B和Brandt·...

AGL1 Electro感受态细胞的背景与应用!
AGL1 Electro感受态细胞是以为C58,RecA型背...